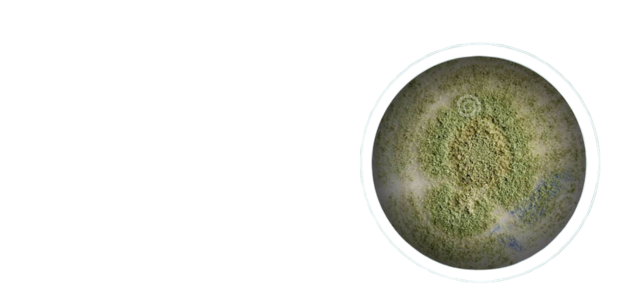
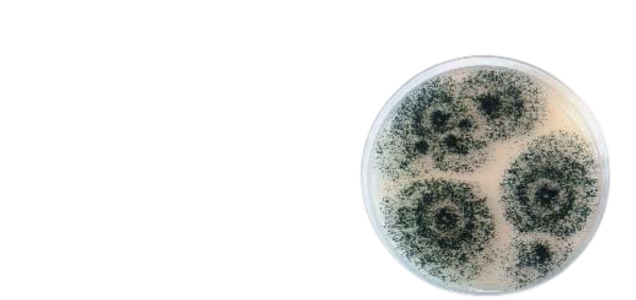

Hatékonyan támogatja az emésztést és az anyagcserét természetes enzimekkel.
Enzim Komplex - 60db
Címkék: Laktáz, Betain, Homocisztein-metabolizmus, Tápanyag-felszívódás
A Nordvital Enzim Komplex készítmény nyolcféle enzimet tartalmaz, amelyeket úgy állítottunk össze, hogy egymást jól kiegészítő formulát alkossanak. A termék tartalmaz laktázt, betaint, valamint más népszerű enzimkomponenseket is, így jól illeszthető a tudatos étrend-kiegészítésbe.
Rendelését 3 napon belül kiszállítjuk az ország bármely részére. Szállítási költség belföldre: 1.200 - 1.690 Ft között.

Energia a mindennapokhoz természetes összetevőkkel

Támogatja az emésztési folyamatokat

Természetes segítség laktózérzékenyeknek

Kulcs a homocisztein anyagcseréhez

Komplex támogatás
Támogatja az emésztési folyamatokat
Természetes segítség laktózérzékenyeknek
Kulcs a homocisztein anyagcseréhez
Komplex támogatás




Főbb összetevők
Proteáz enzim
Papain enzim

Alfa-amiláz enzim

Celluláz enzim

Laktáz enzim

Bromelain enzim

Alfa-galaktozidáz enzim
Betain-hidroklorid

Gyakran ismételt kérdések
Hatóanyag
Összetevők
Adagolás
Hány éves kortól szedhető
Tárolás
Figyelmeztetés

Az étrend-kiegészítő nem helyettesíti a kiegyensúlyozott, változatos étrendet és az egészséges életmódot.